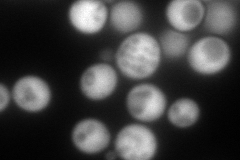
YDR226W
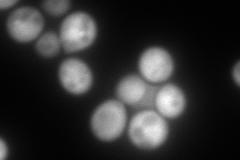
YDR226W
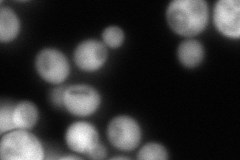
YDR226W
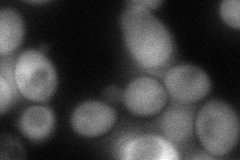
YDR226W
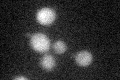
YDR226W
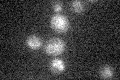
YDR226W

View description
Adenylate kinase, required for purine metabolism; localized to the cytoplasm and the mitochondria; lacks cleavable signal sequence
Localization:
Intensity:
Fold change:
Significance:
-
C’ GFP library in SD

below threshold19.03 -
N' NOP1pr-GFP in SD
cytosol342.338 -
N' TEF2pr-mCherry in SD
cytosol403.298 -
N' NATIVEpr-GFP in SD
cytosol324.059 -
N' TEF2pr-VC and Cyto-VN in SD
cytosol84.6365 -
C’ GFP library in SD+DTT
cytosol18.910.99No -
C’ GFP library in SD+H2O2

cytosol16.650.87No -
C’ GFP library in Starvation Media
cytosol15.330.8No -
C’ GFP library on the background of Pup2-DaMP

below threshold -
C’ GFP library on the background of CCT mutant

below threshold19.90081.04552No
